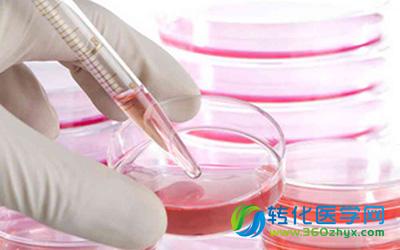
重磅！国务院发布《中国制造2025》，生物医药及高性能医疗器械为重点领域

政府或将发文规范细胞治疗 筛选大型医疗机构开展
一位免疫细胞与干细胞治疗领域专家在券商组织的电话会议上表示,卫计委即将出台细胞治疗规范文件,并选择国内有基础和实力的医疗机构开展细胞治疗的临床研究,实现细胞治疗临床应用规范化。
卫计委:医院评审不会停
近日,国家卫生计生委医政医管局综合评价处处长刘勇明确表示:“等级医院评审不会停,只是可能会在评审方式上进行改进。”
重磅!国务院发布《中国制造2025》,生物医药
5月19日,国务院发布了《中国制造2025》,明确了中国制造业“由大到强”的发展路径,是我国实施制造强国战略第一个十年的行动纲领。通知提出通过“三步走”实现制造强国的战略目标:到2025年迈入制造强国行列;到2035年我国制造业整体达到世界制造强国阵营中等水平;到新中国成立一百年时,我制造业大国地位更加巩固,综合实力进入世界制造强国前列。工信部部长苗圩表示,这意味着,到2025年,我国综合指数接近德国、日本实现工业化时的制造强国水平,基本实现工业化,进入世界制造业强国第二方阵。
抗癌药紫杉醇精准用药新指标锁定
哈医大遗传学教研室周春水课题组联合美国哈佛医学院专家在一项基础医学研究中,发现PDCD4蛋白表达水平与紫杉醇的敏感性呈正相关,由此为紫杉醇的个体化用药提供了精确指标。
国务院发文:试点城市所有公立医院推进医药分开
根据党的十八大、十八届二中、三中、四中全会精神和《中共中央国务院关于深化医药卫生体制改革的意见》、《国务院关于印发“十二五”期间深化医药卫生体制改革规划暨实施方案的通知》(国发〔2012〕11号)要求,为加强对城市公立医院(地级市辖区及以上城市公立医院)综合改革试点的指导,经国务院同意,现提出如下意见。
国务院办公厅:取消县级公立医院药品加成收入
国务院办公厅今日发布《关于全面推开县级公立医院综合改革的实施意见》(以下简称《意见》)。《意见》要求,所有县级公立医院推进医药分开,积极探索多种有效方式改革以药补医机制,取消药品加成(中药饮片除外)。
“精准医学”有望写入国家“十三五”科技规划
国家层面通过组织专家论证和讨论,一致认为现在开展精准医疗研究是整个医学界的重大机遇。
西门子医疗中国贿1000家医院被查?工商总局否
昨晚,国家工商总局在官网发布关于媒体报道“工商总局对西门子医疗部门展开商业贿赂调查”一事的回应,否认调查西门子公司商业贿赂。
李克强作出重要批示强调:在方便群众就医减轻看病
李克强对2015年深化医药卫生体制改革工作电视电话会议作出重要批示强调 以公平可及、群众受益为出发点和立足点 在方便群众就医减轻看病用药负担上取得更大实效 刘延东出席会议并讲话 2015年深化医药卫生体制改革工作电视电话会议29日在京召开,中共中央政治局常委、国务院总理李...
安徽重点整治非法体外诊断试剂 首先从企业和医院
假牙有多假、美瞳不太美、安全套不安全、诊断试剂瞎诊断……今年,安徽省食品药品监督管理局将对上述医疗器械乱象逐一整治。4月22日,正式在全省开展体外诊断试剂“百日风险大排查”和专项整治行动。
德国科研人员在未来十年将获得至少50亿元科研资
德国执政党同意在2018年至2028年间,至少将50亿欧元(约54以美元)投入到科学研究中。近日的这个宣布,虽然是没有政府承诺,但是这个迹象强烈的表明,德国将继续其对科学研究的健康的支持。
栏目推荐
| 2017年中国生物 |
| 振奋!上海敲定优先 |
| 重磅!32家国家临 |
| 重磅!人社部:36 |
 腾讯登录
腾讯登录